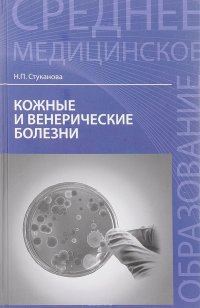

18+
На сайте представлено только описание и выходные данные книги «Нервные и психические болезни. Учебное пособие С. М. Бортникова, С. Г. Беседовский, Т. В. Зубахина». Сайт не является распространителем книги. Сайт не предоставляет возможности купить, читать онлайн или скачать бесплатно книгу «Нервные и психические болезни. Учебное пособие С. М. Бортникова, С. Г. Беседовский, Т. В. Зубахина». Сайт предназначен для лиц старше 18 лет. Если вам не исполнилось 18 лет - незамедлительно покиньте сайт. Оставаясь на сайте вы подтверждаете, что вам исполнилось 18 лет.
Незаконное потребление наркотических средств, психотропных веществ, их аналогов причиняет вред здоровью, их незаконный оборот запрещен и влечет установленную законодательством ответственность
Учебное пособие соответствует федеральным государственным образовательным стандартам СПО. Рассматривается организация неврологической помощи, принципы сестринского ухода; анатомия, функции и клинические проявления поражений нервной системы. Изложены этиология, клиника, диагностика, методы лечения и профилактики наиболее распространенных нервных болезней.В пособии рассматривается организация психиатрической помощи, дается характеристика основных психопатологических синдромов, принципов лечения и особенностей ухода. В частной психиатрии освещены этиопатогенез, клиника и лечение основных психических заболеваний. Особое внимание уделено оказанию доврачебной помощи.Предназначен для студентов медицинских колледжей по специальностям: "Лечебное дело", "Акушерское дело", "Сестринское дело", а также для практикующих фельдшеров и других медработников. Это и многое другое вы найдете в книге Нервные и психические болезни. Учебное пособие (С. М. Бортникова, Т. В. Зубахина, С. Г. Беседовский)
| Полное название книги | С. М. Бортникова, С. Г. Беседовский, Т. В. Зубахина Нервные и психические болезни. Учебное пособие |
| Тип | Книга |
| Авторы | С. М. Бортникова, С. Г. Беседовский, Т. В. Зубахина |
| Категории | Для техникумов и вузов, Образование и наука, Книги |
| ISBN | 9785222293751 |
| Возрастное ограничение | 18 |
| Издательство | Феникс |
| Год | 2017 |
| Название транслитом | nervnye-i-psihicheskie-bolezni-uchebnoe-posobie-s-m-bortnikova-s-g-besedovskiy-t-v-zubahina |
| Просмотров | 17 |
| Рейтинг izbe.ru | 0,0 |

Мари Мур

Брук Лин

Конкордия Антарова

Дэниел Киз

Абрахам Вергезе

Аида Синицына

Вадим Зеланд

Сергей Лукьяненко

Роберт Грин

Виктор Дашкевич

Роман Прокофьев

Пауло Коэльо